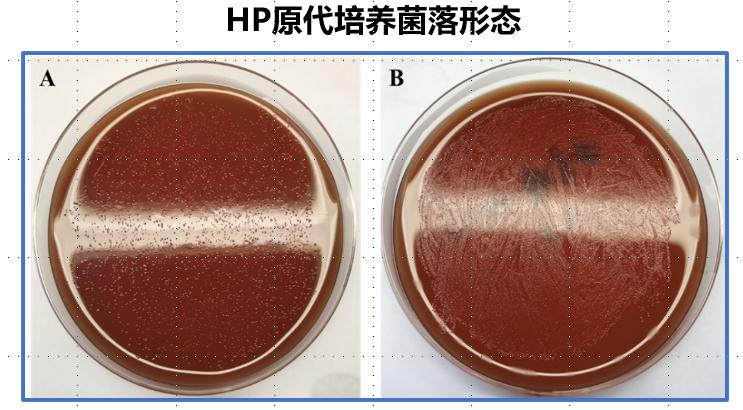

- +1
胃癌的元凶竟是它——幽门螺杆菌检测篇
原创 季颖婕 东方内镜
胃癌的元凶竟是它!
——幽门螺杆菌检测篇
东方内镜
幽门螺杆菌(Helicobacter pylori, HP)的感染是胃癌的1类致癌因素,也是许多胃病的罪魁祸首。
将近100%HP感染者伴有慢性胃炎,约95%的十二指肠溃疡和70%的胃溃疡由HP引起,63.4%的胃癌由HP引起。
一、什么是幽门螺杆菌?
 幽门螺杆菌(即HP)是一种寄生在胃内的细菌,目前我国的感染率约60%。所谓病从口入,幽门螺杆菌大多在儿童的时候从口中咽下,定植在胃的幽门部的胃粘膜表面,慢慢地从胃窦开始往胃体方向破坏我们的胃粘膜,从而引起胃炎、萎缩、肠化乃至消化性溃疡、胃癌、MALT淋巴瘤等一系列的疾病。
幽门螺杆菌(即HP)是一种寄生在胃内的细菌,目前我国的感染率约60%。所谓病从口入,幽门螺杆菌大多在儿童的时候从口中咽下,定植在胃的幽门部的胃粘膜表面,慢慢地从胃窦开始往胃体方向破坏我们的胃粘膜,从而引起胃炎、萎缩、肠化乃至消化性溃疡、胃癌、MALT淋巴瘤等一系列的疾病。 二、哪些情况需要检查幽门螺杆菌?
二、哪些情况需要检查幽门螺杆菌?根除HP主要是为了预防20年后胃炎进展为胃癌,治愈消化道溃疡、胃MALT淋巴瘤等疾病,并切断感染他人的传播途径。
在出现以下症状时建议筛查幽门螺杆菌:
 三、幽门螺杆菌有哪些检查方法?
三、幽门螺杆菌有哪些检查方法?幽门螺杆菌的检测方法分为侵入性检查(经内镜)和非侵入性检查(不经内镜)。
HP粪便抗原试验、呼气试验或内镜活检中三项有一项阳性,则提示有HP感染。接下来我们来一个介绍这些方法的不同之处。
 1、HP粪便抗原检查
1、HP粪便抗原检查粪便HP抗原的检测能更早的检测出人是否感染幽门螺杆菌。
人胃上皮细胞每1~3天更新一次,在更新过程中,这些上皮细胞以及表面定植的HP脱落后经幽门至小肠和大肠,最后随粪便排出,因而可在粪便中检测到HP抗原。由此可见,粪便HP抗原检测最多在人感染后1~3天内可检测到。粪便检测HP抗原只要是检测到是阳性,就说明被检测者现症感染了HP。
该方法适用于婴幼儿、儿童幽门螺杆菌感染的检测、幽门螺杆菌根治疗效评价、幽门螺杆菌感染的流行病学调查等,更多地用于科学研究方面。
2、HP血清抗体试验
由于Hp感染后血清中抗体出现需要半年左右的时间,故早期查抗体易出现假阴性。HP被根除后,抗体水平下降缓慢,一般1~2年才能转阴,在此期间检测结果阳性则表示患者可能曾经感染过HP或正在感染期间,不能区分感染的具体情况。
对于从未治疗过HP的现症感染患者有一定参考价值,多用于Hp感染的流行病学调查。
 3、13C呼气试验
3、13C呼气试验HP检测的金标准是13C呼气实验。注意在做呼气试验前要空腹,禁食禁水,并且检查前一个月内不能服用胃药(PPI如拉唑类、H2受体拮抗剂如法莫替丁、胃复春等中成药)或抗生素,检查时先对试管吹气,服用碳13胶囊后静坐半小时后再吹气,当天就能出结果。
13C呼气实验是没有辐射的,孕妇儿童都可以做。
 13C标记的尿素在尿素酶作用下,分解成13CO2,13CO2从胃肠道吸收经血液循环到达肺随呼气排出。收集呼出的气体,测定其中的12CO2和 13CO2,并与本底比较,就可间接判断有无HP感染。正常人没有HP,13C-尿素不分解,13C-尿素经泌尿系统排出,呼出的气体中就没有13CO2。
13C标记的尿素在尿素酶作用下,分解成13CO2,13CO2从胃肠道吸收经血液循环到达肺随呼气排出。收集呼出的气体,测定其中的12CO2和 13CO2,并与本底比较,就可间接判断有无HP感染。正常人没有HP,13C-尿素不分解,13C-尿素经泌尿系统排出,呼出的气体中就没有13CO2。 13C呼气试验的测定结果以超基准值DOB表示 ( Delta Over Baseline)
13C呼气试验的测定结果以超基准值DOB表示 ( Delta Over Baseline)幽门螺杆菌诊断阳性:DOB值>4.4 幽门螺杆菌诊断阴性:DOB值<3.6
 四、HP感染的内镜下表现?
四、HP感染的内镜下表现? 五、HP的内镜下活检诊断?
五、HP的内镜下活检诊断?胃镜检查前1月内建议患者未服用过抗生素、抑酸药物(H2受体阻断剂、PPI)、胃中成药(摩罗丹、胃复春等)。
内镜检查时通过活检钳取胃粘膜组织一块,行病理检查,如有慢性活动性炎症(++至+++)则提示HP现症感染;同时活检也能判断胃的萎缩、肠化程度,有无异型增生、癌前病变等情况。
 取下的胃粘膜还能行以下检查判断HP感染情况:
取下的胃粘膜还能行以下检查判断HP感染情况: 胃窦部取一块胃黏膜组织立即用无菌牙签插入快速尿素酶试剂板,贴上贴纸,室温下数分钟内试剂颜色由浅黄色变为粉红色,则认为此胃黏膜幽门螺杆菌阳性,否则为阴性。
胃窦部取一块胃黏膜组织立即用无菌牙签插入快速尿素酶试剂板,贴上贴纸,室温下数分钟内试剂颜色由浅黄色变为粉红色,则认为此胃黏膜幽门螺杆菌阳性,否则为阴性。取下的胃粘膜在培养皿上进行培养,查看菌落形态:幽门螺杆菌菌落在菌落较少时,肉眼下呈半透明、针尖样大小的圆形扁平菌落(图A),当菌量较大时,可形成油亮样半透明的菌苔(图B)。
HE染色能直接观察到胃小凹或胃窦处表面上皮内的HP
HE染色能直接观察到胃小凹或胃窦处表面上皮内的HP 六、根除前一定要做胃镜吗?
六、根除前一定要做胃镜吗? 检测幽门螺杆菌的方法有多种,
检测幽门螺杆菌的方法有多种,各种检测方法因人而异不同选择,
除菌后评估及耐药等特殊病例也需要各种方法结合起来综合分析。
上海市东方医院设HP专病门诊,常规开展HP检测、培养+药敏试验,
有专业内镜团队及高清内镜提供HP相关性疾病的内镜下诊断及治疗。
欢迎您到东方医院进行全面的
胃健康评估和幽门螺杆菌检测,
守护您的健康,
防治胃癌从我做起!
审核:王玉 李貌
排版:凌小雪
本文为澎湃号作者或机构在澎湃新闻上传并发布,仅代表该作者或机构观点,不代表澎湃新闻的观点或立场,澎湃新闻仅提供信息发布平台。申请澎湃号请用电脑访问http://renzheng.thepaper.cn。





- 报料热线: 021-962866
- 报料邮箱: news@thepaper.cn
互联网新闻信息服务许可证:31120170006
增值电信业务经营许可证:沪B2-2017116
© 2014-2026 上海东方报业有限公司




